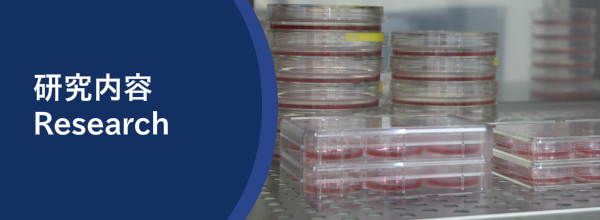

By using the AID (Auxin-Inducible Degron) technology developed by us, we are currently studying the mechanisms maintaining the integrity of chromosomal DNA, misregulation of which can lead to cellular senescence, genetic disorders or cancer formation. Our findings provide a foundation of developing a therapy for people suffering from these disorders.
New genetics using AID in human cells
It is now possible to construct conditional human cells by using the AID technology, which was originally developed by us (see the page of “the AID technology”). It is therefore possible to characterize essential genes for cellular viability, which are estimated to be 9% of all genes encoded in the genome. We are planning to characterize large numbers of these essential genes.
Evolution of AID-based expression control
For a better conditional expression control by AID, we use auixin analogs and improve the CRISPR/Case-based gene editing. We are also applying AID to stem cells as well.
Human cells have multiple mechanisms for maintenance of replication forks
Human cells have to replicate 2 m of genomic DNA for proliferation. Replication forks encounter many problems when they unwind double-strand DNA during DNA replication. To deal with the problems, cells have multiple mechanisms. We study those defense mechanisms by using the AID technology for depleting proteins at replication forks. We also study the relationship between DNA replication and homologous recombination, both of which are important for cellular proliferation and maintenance of genomic integrity.
NIG webiner (Feb 3rd, 2021)
Interview (in Japanese)
Public lecture (in Japanese)




















